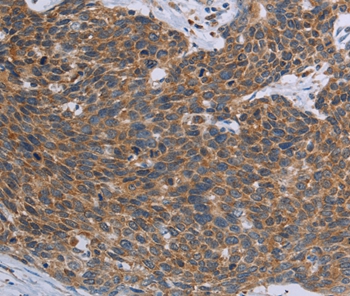

Western blot analysis of extracts of various cell lines using TNPO1 Polyclonal Antibody at dilution of 1:1000.
TNPO1 Polyclonal Antibody
E-AB-65625
Product group Antibodies
Overview
- SupplierElabscience
- Product NameTNPO1 Polyclonal Antibody
- Delivery Days Customer12
- CertificationResearch Use Only
- Scientific DescriptionThis gene encodes the beta subunit of the karyopherin receptor complex which interacts with nuclear localization signals to target nuclear proteins to the nucleus. The karyopherin receptor complex is a heterodimer of an alpha subunit which recognizes the nuclear localization signal and a beta subunit which docks the complex at nucleoporins. Alternate splicing of this gene results in two transcript variants encoding different proteins.
- UNSPSC12352203